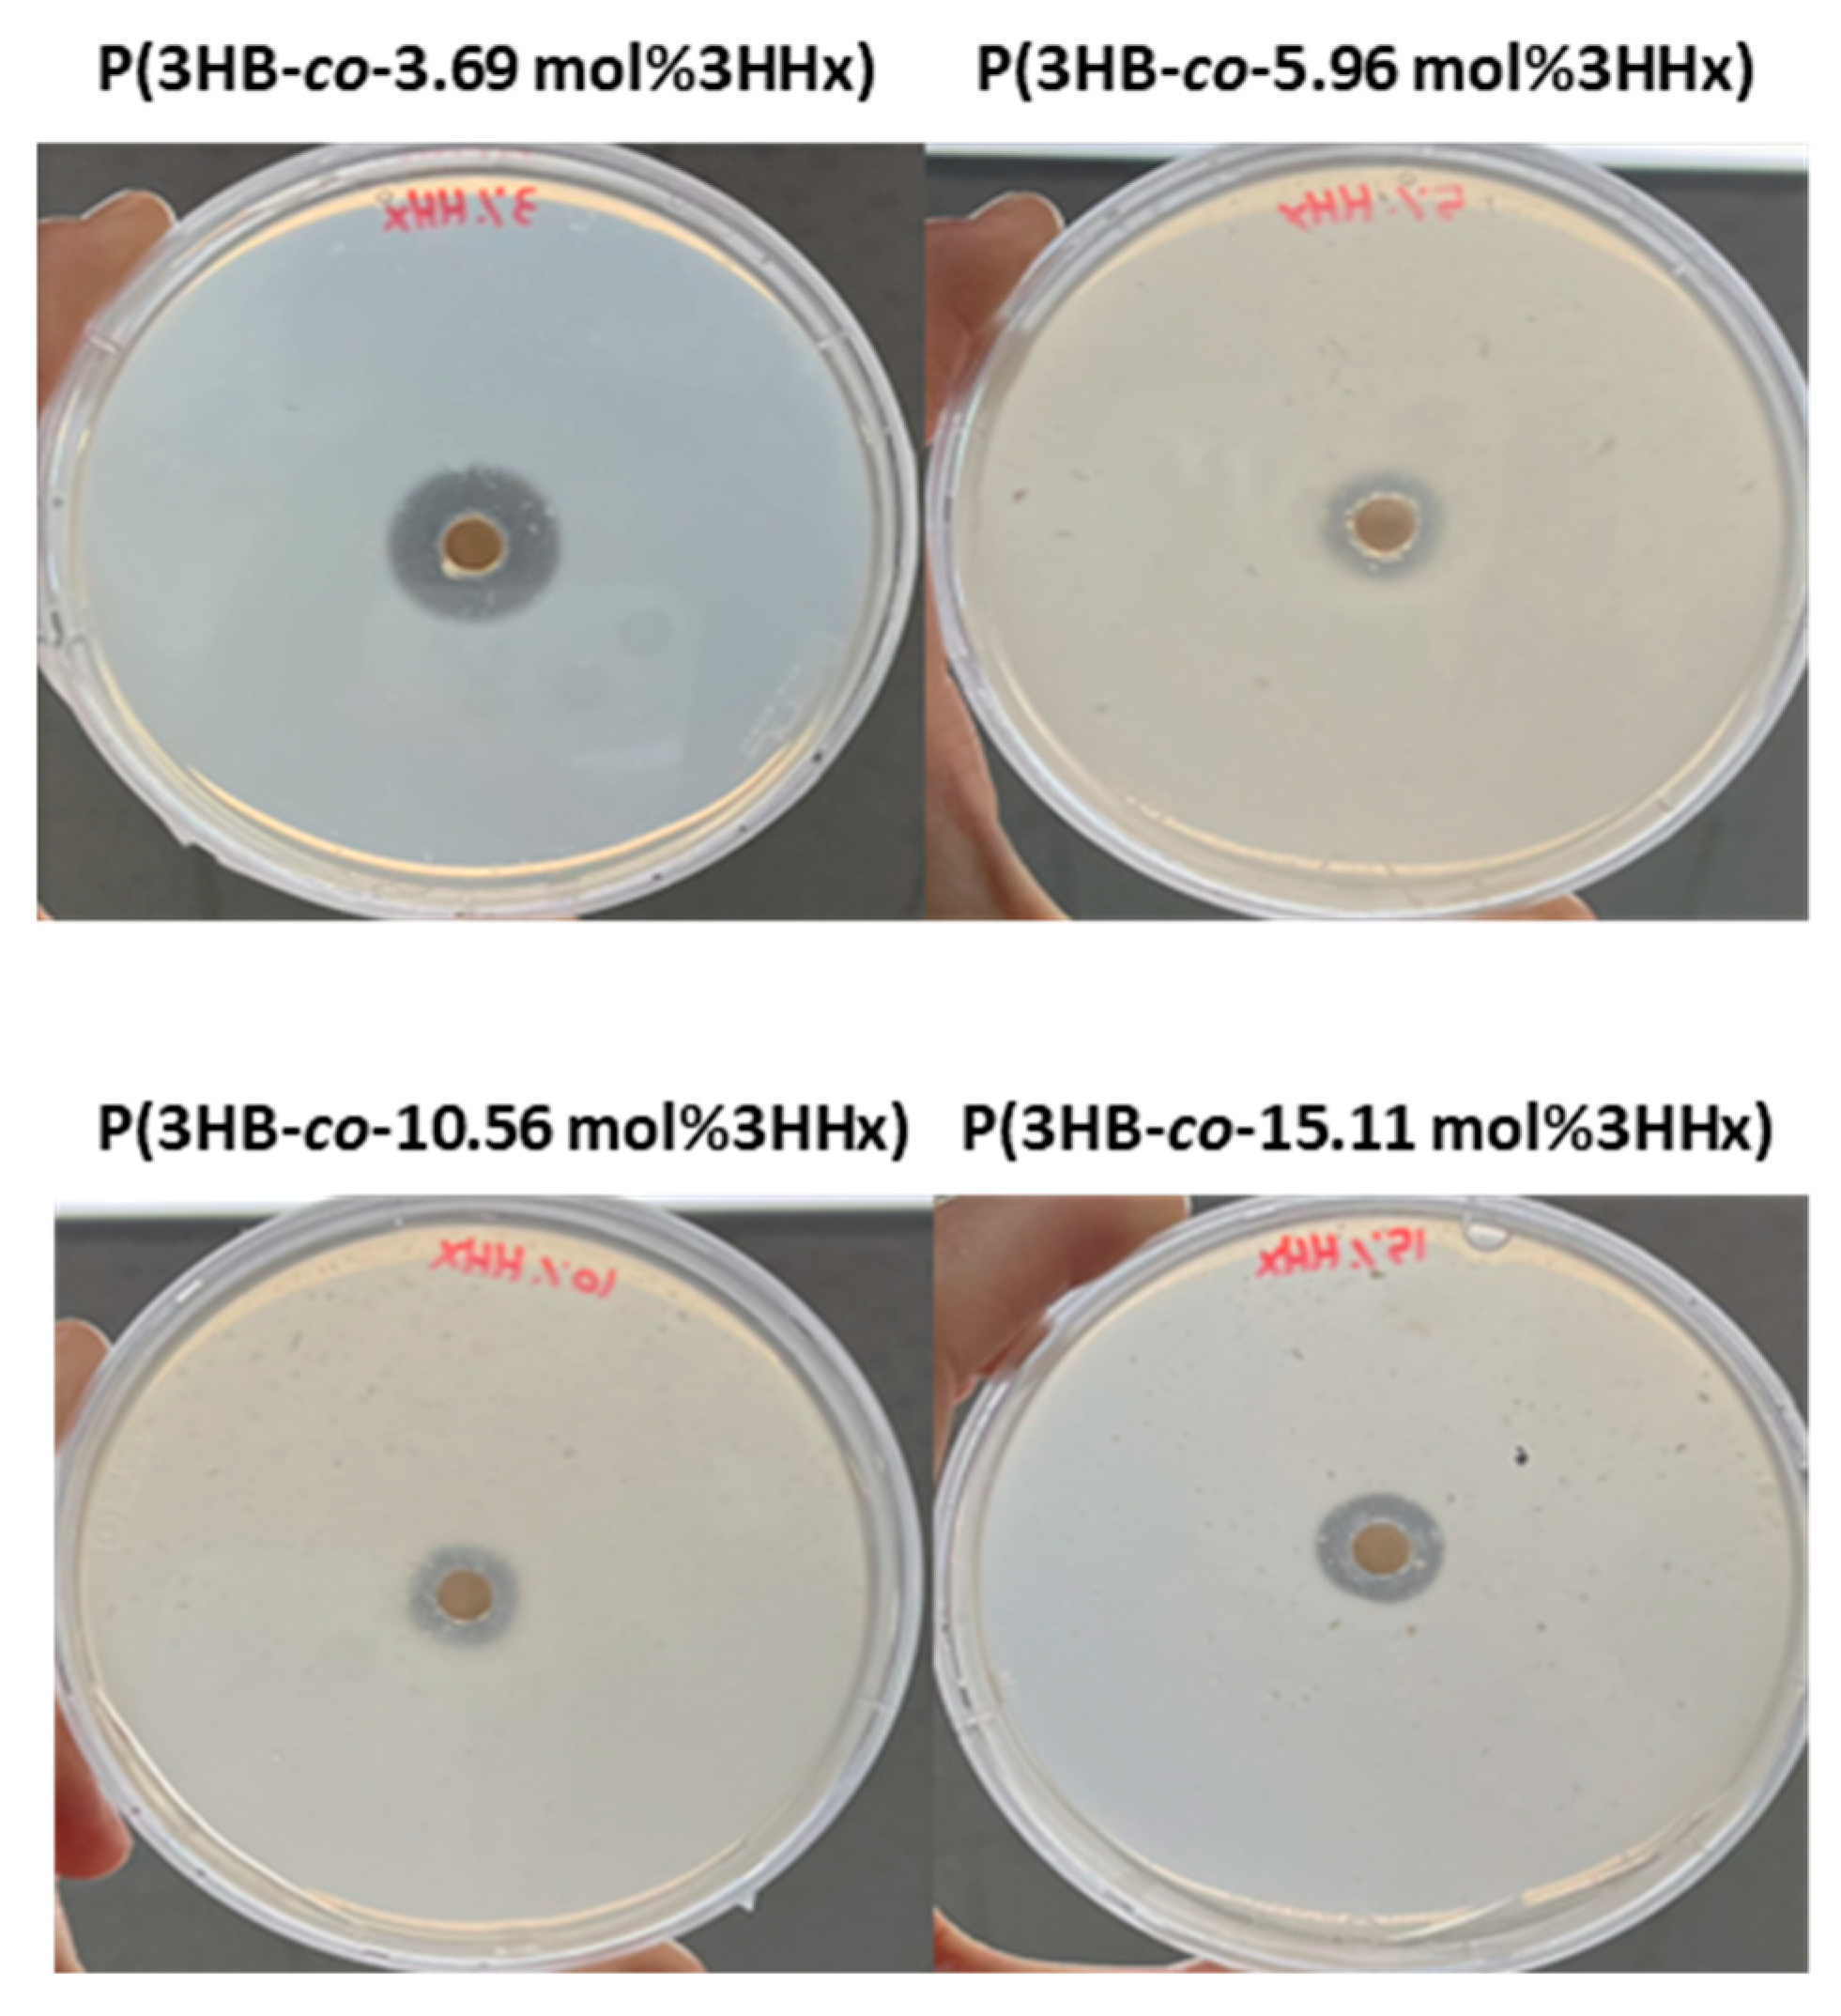
Polymers 16 03077 g004

Evaluation of Blended Poly(3-hydroxybutyrate-co-3-hydroxyhexanoate) Properties Containing Various 3HHx Monomers
Abstract
1. Introduction
2. Materials and Methods
2.1. Bacterial Strains
2.2. Fed-Batch Fermentation to Produce P(3HB) and P(3HB-co-3HHx)
2.3. Preparation of P(3HB) Blending with P(3HB-co-20 mol%3HHx)
2.4. Gel Permeation Chromatography (GPC)
2.5. Differential Scanning Calorimetry (DSC)
2.6. Analysis of Mechanical Properties
2.7. Spectroscopy
2.7.1. Fourier Transform Infrared Spectroscopy (FT-IR)
2.7.2. H Nuclear Magnetic Resonance (1H NMR) Spectroscopy
2.7.3. UV-Visible Spectroscopy (UV-Vis)
2.8. Clear Zone Test for Selecting P(3HB-co-3HHx) Degrading Strain
2.9. Gas Chromatography-Mass Spectrometry (GC-MS) Analysis
3. Results and Discussion
3.1. Determination of 3HHx Mole Fractions of P(3HB-co-3HHx)
3.2. Comparison of Original and Blended P(3HB-co-3HHx) with FT-IR, NMR and UV Spectra
3.3. GPC of P(3HB-co-3HHx) Blends
3.4. Thermal Characterization of P(3HB-co-3HHx) Blends
3.5. Mechanical Properties of P(3HB-co-3HHx) with Various Fractions of 3HHx Monomer
3.6. Degradation of Blended P(3HB-co-3HHx) by Bacteria Strains
3.6.1. Clear Zone Test to Confirm Biodegradability of Blended P(3HB-co-3HHx)
3.6.2. Degradation of of P(3HB-co-3HHx) with Various 3HHx Mole Fractions
4. Conclusions
Supplementary Materials
Author Contributions
Funding
Institutional Review Board Statement
Data Availability Statement
Conflicts of Interest
References
- Narancic, T.; Cerrone, F.; Beagan, N.; O’Connor, K.E. Recent Advances in Bioplastics: Application and Biodegradation. Polymers 2020, 12, 920. [Google Scholar] [CrossRef] [PubMed]
- Dilkes-Hoffman, L.S.; Pratt, S.; Lant, P.A.; Laycock, B. The Role of Biodegradable Plastic in Solving Plastic Solid Waste Accumulation. In Plastics to Energy: Fuel, Chemicals, and Sustainability Implications; William Andrew Publishing: Amsterdam, The Netherlands, 2018. [Google Scholar]
- Moshood, T.D.; Nawanir, G.; Mahmud, F.; Mohamad, F.; Ahmad, M.H.; AbdulGhani, A. Biodegradable Plastic Applications towards Sustainability: A Recent Innovations in the Green Product. Clean. Eng. Technol. 2022, 6, 100404. [Google Scholar] [CrossRef]
- Behera, S.; Priyadarshanee, M.; Vandana Das, S. Polyhydroxyalkanoates, the Bioplastics of Microbial Origin: Properties, Biochemical Synthesis, and Their Applications. Chemosphere 2022, 294, 133723. [Google Scholar] [CrossRef] [PubMed]
- Grothe, E.; Chisti, Y. Poly(β-Hydroxybutyric Acid) Thermoplastic Production by Alcaligenes Latus: Behavior of Fed-Batch Cultures. Bioprocess. Eng. 2000, 22, 441–449. [Google Scholar] [CrossRef]
- Beckers, V.; Poblete-Castro, I.; Tomasch, J.; Wittmann, C. Integrated Analysis of Gene Expression and Metabolic Fluxes in PHA-Producing Pseudomonas Putida Grown on Glycerol. Microb. Cell Fact. 2016, 15, 73. [Google Scholar] [CrossRef]
- Shokr, A.; Abd-Elsalam, O.; Hamedo, H.; Elshafey, N. Isolation and Identification of Polyhydroxybutyrate (PHB)-Producing Microorganisms from Various Sources in North Sinai. Catrina Int. J. Environ. Sci. 2023, 27, 23–31. [Google Scholar] [CrossRef]
- Mohapatra, S.; Pattnaik, S.; Maity, S.; Sharma, S.; Akhtar, J.; Pati, S.; Samantaray, D.P.; Varma, A. Comparative Analysis of PHAs Production by Bacillus Megaterium OUAT 016 under Submerged and Solid-State Fermentation. Saudi J. Biol. Sci. 2020, 27, 1242–1250. [Google Scholar] [CrossRef]
- Gęsicka, A.; Gutowska, N.; Palaniappan, S.; Oleskowicz-Popiel, P.; Łężyk, M. Enrichment of Mixed Methanotrophic Cultures Producing Polyhydroxyalkanoates (PHAs) from Various Environmental Sources. Sci. Total Environ. 2024, 912, 168844. [Google Scholar] [CrossRef]
- Troschl, C.; Meixner, K.; Drosg, B. Cyanobacterial PHA Production—Review of Recent Advances and a Summary of Three Years’ Working Experience Running a Pilot Plant. Bioengineering 2017, 4, 26. [Google Scholar] [CrossRef]
- Tripathi, L.; Wu, L.P.; Chen, J.; Chen, G.Q. Synthesis of Diblock Copolymer Poly-3-Hydroxybutyrate-Block-Poly-3-Hydroxyhexanoate [PHB-b-PHHx] by a β-Oxidation Weakened Pseudomonas Putida KT2442. Microb. Cell Fact. 2012, 11, 44. [Google Scholar] [CrossRef]
- Fernandez-Bunster, G.; Pavez, P. Novel Production Methods of Polyhydroxyalkanoates and Their Innovative Uses in Biomedicine and Industry. Molecules 2022, 27, 8351. [Google Scholar] [CrossRef] [PubMed]
- Sharma, S.; Sharma, P.; Sharma, V.; Bajaj, B.K. Polyhydroxybutyrate as an Eco-Friendly Alternative of Synthetic Plastics. In Environmental and Agricultural Microbiology: Advances and Applications; Wiley: Hoboken, NJ, USA, 2021. [Google Scholar]
- Kalia, V.C.; Singh Patel, S.K.; Shanmugam, R.; Lee, J.K. Polyhydroxyalkanoates: Trends and Advances toward Biotechnological Applications. Bioresour. Technol. 2021, 326, 124737. [Google Scholar] [CrossRef] [PubMed]
- Albuquerque, P.B.S.; Malafaia, C.B. Perspectives on the Production, Structural Characteristics and Potential Applications of Bioplastics Derived from Polyhydroxyalkanoates. Int. J. Biol. Macromol. 2018, 107, 615–625. [Google Scholar] [CrossRef] [PubMed]
- Gurunathan, T.; Mohanty, S.; Nayak, S.K. A Review of the Recent Developments in Biocomposites Based on Natural Fibres and Their Application Perspectives. Compos. Part A Appl. Sci. Manuf. 2015, 77, 1–25. [Google Scholar] [CrossRef]
- Yeo, J.C.C.; Muiruri, J.K.; Thitsartarn, W.; Li, Z.; He, C. Recent Advances in the Development of Biodegradable PHB-Based Toughening Materials: Approaches, Advantages and Applications. Mater. Sci. Eng. C 2018, 92, 1092–1116. [Google Scholar] [CrossRef]
- Volova, T.G.; Syrvacheva, D.A.; Zhila, N.O.; Sukovatiy, A.G. Synthesis of P(3HB-co-3HHx) Copolymers Containing High Molar Fraction of 3-Hydroxyhexanoate Monomer by Cupriavidus eutrophus B10646. J. Chem. Technol. Biotechnol. 2016, 91, 416–425. [Google Scholar] [CrossRef]
- Volova, T.; Kiselev, E.; Vinogradova, O.; Nikolaeva, E.; Chistyakov, A.; Sukovatiy, A.; Shishatskaya, E. A Glucose-Utilizing Strain, Cupriavidus euthrophus B-10646: Growth Kinetics, Characterization and Synthesis of Multicomponent PHAs. PLoS ONE 2014, 9, e87551. [Google Scholar] [CrossRef]
- Min Song, H.; Chan Joo, J.; Hyun Lim, S.; Jin Lim, H.; Lee, S.; Jae Park, S. Production of Polyhydroxyalkanoates Containing Monomers Conferring Amorphous and Elastomeric Properties from Renewable Resources: Current Status and Future Perspectives. Bioresour. Technol. 2022, 366, 128114. [Google Scholar] [CrossRef]
- Eraslan, K.; Aversa, C.; Nofar, M.; Barletta, M.; Gisario, A.; Salehiyan, R.; Goksu, Y.A. Poly(3-Hydroxybutyrate-co-3-Hydroxyhexanoate) (PHBH): Synthesis, Properties, and Applications—A Review. Eur. Polym. J. 2022, 167, 111044. [Google Scholar] [CrossRef]
- Noda, I.; Green, P.R.; Satkowski, M.M.; Schechtman, L.A. Preparation and Properties of a Novel Class of Polyhydroxyalkanoate Copolymers. Biomacromolecules 2005, 6, 580–586. [Google Scholar] [CrossRef]
- Joyyi, L.; Ahmad Thirmizir, M.Z.; Salim, M.S.; Han, L.; Murugan, P.; Kasuya, K.; Maurer, F.H.J.; Zainal Arifin, M.I.; Sudesh, K. Composite Properties and Biodegradation of Biologically Recovered P(3HB-co-3HHx) Reinforced with Short Kenaf Fibers. Polym. Degrad. Stab. 2017, 137, 100–108. [Google Scholar] [CrossRef]
- Tanaka, K.; Orita, I.; Fukui, T. Production of Poly(3-Hydroxybutyrate-co-3-Hydroxyhexanoate) from CO2 via PH-Stat Jar Cultivation of an Engineered Hydrogen-Oxidizing Bacterium Cupriavidus necator. Bioengineering 2023, 10, 1304. [Google Scholar] [CrossRef] [PubMed]
- Shen, L.; Hu, H.; Ji, H.; Zhang, C.; He, N.; Li, Q.; Wang, Y. Production of Poly(3-Hydroxybutyrate-Co-3-Hydroxyhexanoate) from Excess Activated Sludge as a Promising Substitute of Pure Culture. Bioresour. Technol. 2015, 189, 236–242. [Google Scholar] [CrossRef] [PubMed]
- Tang, H.J.; Neoh, S.Z.; Sudesh, K. A Review on Poly(3-Hydroxybutyrate-Co-3-Hydroxyhexanoate) [P(3HB-Co-3HHx)] and Genetic Modifications That Affect Its Production. Front. Bioeng. Biotechnol. 2022, 10, 1057067. [Google Scholar] [CrossRef]
- Wang, Q.; Luan, Y.; Cheng, X.; Zhuang, Q.; Qi, Q. Engineering of Escherichia Coli for the Biosynthesis of Poly(3-Hydroxybutyrate-co-3-Hydroxyhexanoate) from Glucose. Appl. Microbiol. Biotechnol. 2015, 99, 2593–2602. [Google Scholar] [CrossRef]
- Doi, Y.; Kitamura, S.; Abe, H. Microbial Synthesis and Characterization of Poly(3-Hydroxybutyrate-co-3-Hydroxyhexanoate). Macromolecules 1995, 28, 4822–4828. [Google Scholar] [CrossRef]
- Fukui, T.; Doi, Y. Efficient Production of Polyhydroxyalkanoates from Plant Oils by Alcaligenes eutrophus and Its Recombinant Strain. Appl. Microbiol. Biotechnol. 1998, 49, 333–336. [Google Scholar] [CrossRef]
- Riedel, S.L.; Bader, J.; Brigham, C.J.; Budde, C.F.; Yusof, Z.A.M.; Rha, C.; Sinskey, A.J. Production of Poly(3-Hydroxybutyrate-co-3-Hydroxyhexanoate) by Ralstonia eutropha in High Cell Density Palm Oil Fermentations. Biotechnol. Bioeng. 2012, 109, 74–83. [Google Scholar] [CrossRef]
- Fukui, T.; Doi, Y. Cloning and Analysis of the Poly(3-Hydroxybutyrate-co-3-Hydroxyhexanoate) Biosynthesis Genes of Aeromonas caviae. J. Bacteriol. 1997, 179, 4821–4830. [Google Scholar] [CrossRef]
- Wang, H.; Ye, J.W.; Chen, X.; Yuan, Y.; Shi, J.; Liu, X.; Yang, F.; Ma, Y.; Chen, J.; Wu, F.; et al. Production of PHA Copolymers Consisting of 3-Hydroxybutyrate and 3-Hydroxyhexanoate (PHBHHx) by Recombinant Halomonas Bluephagenesis. Chem. Eng. J. 2023, 466, 143261. [Google Scholar] [CrossRef]
- Favaro, L.; Basaglia, M.; Casella, S. Improving Polyhydroxyalkanoate Production from Inexpensive Carbon Sources by Genetic Approaches: A Review. Biofuels Bioprod. Biorefining 2019, 13, 208–227. [Google Scholar] [CrossRef]
- Bedade, D.K.; Edson, C.B.; Gross, R.A. Emergent Approaches to Efficient and Sustainable Polyhydroxyalkanoate Production. Molecules 2021, 26, 3463. [Google Scholar] [CrossRef] [PubMed]
- Volova, T.G.; Uspenskaya, M.V.; Kiselev, E.G.; Sukovatyi, A.G.; Zhila, N.O.; Vasiliev, A.D.; Shishatskaya, E.I. Effect of Monomers of 3-Hydroxyhexanoate on Properties of Copolymers Poly(3-Hydroxybutyrate-Co 3-Hydroxyhexanoate). Polymers 2023, 15, 2890. [Google Scholar] [CrossRef] [PubMed]
- Neoh, S.Z.; Tan, H.T.; Trakunjae, C.; Chek, M.F.; Vaithanomsat, P.; Hakoshima, T.; Sudesh, K. N-Terminal Truncation of PhaCBP-M-CPF4 and Its Effect on PHA Production. Microb. Cell Fact. 2024, 23, 52. [Google Scholar] [CrossRef]
- Thirumala, M.; Reddy, S.V.; Mahmood, S.K. Production and Characterization of PHB from Two Novel Strains of Bacillus spp. Isolated from Soil and Activated Sludge. J. Ind. Microbiol. Biotechnol. 2010, 37, 271–278. [Google Scholar] [CrossRef]
- Hassan, M.A.; Bakhiet, E.K.; Ali, S.G.; Hussien, H.R. Production and Characterization of Polyhydroxybutyrate (PHB) Produced by Bacillus sp. Isolated from Egypt. J. Appl. Pharm. Sci. 2016, 6, 46–51. [Google Scholar] [CrossRef]
- Tarani, E.; Arvanitidis, I.; Christofilos, D.; Bikiaris, D.N.; Chrissafis, K.; Vourlias, G. Calculation of the Degree of Crystallinity of HDPE/GNPs Nanocomposites by Using Various Experimental Techniques: A Comparative Study. J. Mater. Sci. 2023, 58, 1621–1639. [Google Scholar] [CrossRef]
- Mendonça, T.T.; Gomez, J.G.C.; Buffoni, E.; Sánchez Rodriguez, R.J.; Schripsema, J.; Lopes, M.S.G.; Silva, L.F. Exploring the Potential of Burkholderia sacchari to Produce Polyhydroxyalkanoates. J. Appl. Microbiol. 2014, 116, 815–829. [Google Scholar] [CrossRef]
- Biggs, M.B.; Medlock, G.L.; Kolling, G.L.; Papin, J.A. Metabolic Network Modeling of Microbial Communities. Wiley Interdiscip. Rev. Syst. Biol. Med. 2015, 7, 317–334. [Google Scholar] [CrossRef]
- More, T.T.; Yan, S.; Hoang, N.V.; Tyagi, R.D.; Surampalli, R.Y. Bacterial Polymer Production Using Pre-Treated Sludge as Raw Material and Its Flocculation and Dewatering Potential. Bioresour. Technol. 2012, 121, 425–431. [Google Scholar] [CrossRef]
- Chen, L.J.; Wang, M. Production and Evaluation of Biodegradable Composites Based on PHB-PHV Copolymer. Biomaterials 2002, 23, 2631–2639. [Google Scholar] [CrossRef] [PubMed]
- Mifune, J.; Nakamura, S.; Fukui, T. Engineering of Pha Operon on Cupriavidus necator Chromosome for Efficient Biosynthesis of Poly(3-Hydroxybutyrate-Co-3-Hydroxyhexanoate) from Vegetable Oil. Proc. Polym. Degrad. Stab. 2010, 95, 1305–1312. [Google Scholar] [CrossRef]
- Park, S.L.; Cho, J.Y.; Kim, S.H.; Bhatia, S.K.; Gurav, R.; Park, S.H.; Park, K.; Yang, Y.H. Isolation of Microbulbifer sp. Sol66 with High Polyhydroxyalkanoate-Degrading Activity from the Marine Environment. Polymers 2021, 13, 4257. [Google Scholar] [CrossRef] [PubMed]
- Yang, Y.H.; Brigham, C.J.; Budde, C.F.; Boccazzi, P.; Willis, L.B.; Hassan, M.A.; Yusof, Z.A.M.; Rha, C.; Sinskey, A.J. Optimization of Growth Media Components for Polyhydroxyalkanoate (PHA) Production from Organic Acids by Ralstonia eutropha. Appl. Microbiol. Biotechnol. 2010, 87, 2037–2045. [Google Scholar] [CrossRef]
- Shin, Y.; Kim, H.J.; Choi, T.R.; Oh, S.J.; Kim, S.; Lee, Y.; Choi, S.; Oh, J.; Kim, S.Y.; Lee, Y.S.; et al. Identification of Oil-Loving Cupriavidus necator BM3-1 for Polyhydroxyalkanoate Production and Assessing Contribution of Exopolysaccharide for Vegetable Oil Utilization. Polymers 2024, 16, 1639. [Google Scholar] [CrossRef]
- Ng, K.S.; Ooi, W.Y.; Goh, L.K.; Shenbagarathai, R.; Sudesh, K. Evaluation of Jatropha Oil to Produce Poly(3-Hydroxybutyrate) by Cupriavidus Necator H16. Proc. Polym. Degrad. Stab. 2010, 95, 1365–1369. [Google Scholar] [CrossRef]
- Tran, M.H.; Choi, T.R.; Yang, Y.H.; Lee, O.K.; Lee, E.Y. An Efficient and Eco-Friendly Approach for the Sustainable Recovery and Properties Characterization of Polyhydroxyalkanoates Produced by Methanotrophs. Int. J. Biol. Macromol. 2024, 257, 128687. [Google Scholar] [CrossRef]
- Lee, H.S.; Lee, S.M.; Park, S.L.; Choi, T.R.; Song, H.S.; Kim, H.J.; Bhatia, S.K.; Gurav, R.; Kim, Y.G.; Kim, J.H.; et al. Tung Oil-Based Production of High 3-Hydroxyhexanoate-Containing Terpolymer Poly(3-Hydroxybutyrate-Co-3-Hydroxyvalerate-Co-3-Hydroxyhexanoate) Using Engineered Ralstonia Eutropha. Polymers 2021, 13, 1084. [Google Scholar] [CrossRef]
- Shin, N.; Kim, S.H.; Oh, J.; Kim, S.; Lee, Y.; Shin, Y.; Choi, S.; Bhatia, S.K.; Kim, Y.G.; Yang, Y.H. Reproducible Polybutylene Succinate (PBS)-Degrading Artificial Consortia by Introducing the Least Type of PBS-Degrading Strains. Polymers 2024, 16, 651. [Google Scholar] [CrossRef]
- Bhatia, S.K.; Gurav, R.; Choi, T.R.; Jung, H.R.; Yang, S.Y.; Moon, Y.M.; Song, H.S.; Jeon, J.M.; Choi, K.Y.; Yang, Y.H. Bioconversion of Plant Biomass Hydrolysate into Bioplastic (Polyhydroxyalkanoates) Using Ralstonia Eutropha 5119. Bioresour. Technol. 2019, 271, 306–315. [Google Scholar] [CrossRef]
- Jung, H.J.; Kim, B.; Choi, T.R.; Oh, S.J.; Kim, S.; Lee, Y.; Shin, Y.; Choi, S.; Oh, J.; Park, S.Y.; et al. Novel Differential Scanning Calorimetry (DSC) Application to Select Polyhydroxyalkanoate (PHA) Producers Correlating 3-Hydroxyhexanoate (3-HHx) Monomer with Melting Enthalpy. Bioprocess. Biosyst. Eng. 2024, 47, 1619–1631. [Google Scholar] [CrossRef] [PubMed]
- Petersen, K.; Nielsen, P.V.; Olsen, M.B. Physical and Mechanical Properties of Biobased Materials-Starch, Polylactate and Polyhydroxybutyrate. Starch/Staerke 2001, 53, 356–361. [Google Scholar] [CrossRef]
- Nasab, M.S.; Tabari, M.; Azizi, M.H. Morphological and Mechanical Properties of Poly (Lactic Acid)/Zinc Oxide Nanocomposite Films. Nanomed. Res. J. 2018, 3, 96–101. [Google Scholar] [CrossRef]
- Donati, N.; Spada, J.C.; Tessaro, I.C. Recycling Rice Husk Ash as a Filler on Biodegradable Cassava Starch-Based Foams. Polym. Bull. 2023, 80, 10231–10248. [Google Scholar] [CrossRef]
- ASTM D882; Standard Test Method for Tensile Properties of Thin Plastic Sheeting. ASTM International: West Conshohocken, PA, USA, 2012.
- Mahato, K.K.; Rathore, D.K.; Prusty, R.K.; Dutta, K.; Ray, B.C. Tensile Behavior of MWCNT Enhanced Glass Fiber Reinforced Polymeric Composites at Various Crosshead Speeds. In Proceedings of the IOP Conference Series. Mater. Sci. Eng. 2017, 178, 012006. [Google Scholar] [CrossRef]
- Shin, N.; Kim, S.H.; Cho, J.Y.; Hwang, J.H.; Kim, H.J.; Oh, S.J.; Park, S.H.; Park, K.; Bhatia, S.K.; Yang, Y.H. Fast Degradation of Polycaprolactone/Poly(Butylene Adipate-Co-Terephthalate) Blends by Novel Bacillus Strain NR4 with Broad Degrading Activity. J. Polym. Environ. 2023, 32, 898–912. [Google Scholar] [CrossRef]
- Yanagisawa, Y.; Nakagome, H.; Tennmei, K.; Hamada, M.; Yoshikawa, M.; Otsuka, A.; Hosono, M.; Kiyoshi, T.; Takahashi, M.; Yamazaki, T.; et al. Operation of a 500 MHz High Temperature Superconducting NMR: Towards an NMR Spectrometer Operating beyond 1 GHz. J. Magn. Reson. 2010, 203, 274–282. [Google Scholar] [CrossRef]
- Samrot, A.V.; Samanvitha, S.K.; Shobana, N.; Renitta, E.R.; Kumar, P.S.; Kumar, S.S.; Abirami, S.; Dhiva, S.; Bavanilatha, M.; Prakash, P.; et al. The Synthesis, Characterization and Applications of Polyhydroxyalkanoates (Phas) and Pha-Based Nanoparticles. Polymers 2021, 13, 3302. [Google Scholar] [CrossRef]
- Zhou, L.; Deng, D.; Zhang, Y.; Zhou, W.; Jiang, Y.; Liu, Y. Isolation of a Facultative Anaerobic Exoelectrogenic Strain LZ-1 and Probing Electron Transfer Mechanism in Situ by Linking UV/Vis Spectroscopy and Electrochemistry. Biosens. Bioelectron. 2017, 90, 264–268. [Google Scholar] [CrossRef]
- Cho, J.Y.; Park, S.L.; Kim, S.H.; Jung, H.J.; Cho, D.H.; Kim, B.C.; Bhatia, S.K.; Gurav, R.; Park, S.H.; Park, K.; et al. Novel Poly(Butylene Adipate-Co-Terephthalate)-Degrading Bacillus sp. JY35 from Wastewater Sludge and Its Broad Degradation of Various Bioplastics. Waste Manag. 2022, 144, 1–10. [Google Scholar] [CrossRef]
- Harjanti, D.W.; Wahyono, F.; Ciptaningtyas, V.R. Effects of Different Sterilization Methods of Herbal Formula on Phytochemical Compounds and Antibacterial Activity against Mastitis-Causing Bacteria. Vet. World 2020, 13, 1187–1192. [Google Scholar] [CrossRef] [PubMed]
- Ateş, F.; Işikdaǧ, M.A. Evaluation of the Role of the Pyrolysis Temperature in Straw Biomass Samples and Characterization of the Oils by GC/MS. Energy Fuels 2008, 22, 1936–1943. [Google Scholar] [CrossRef]
- Fukami, Y.; Maeda, Y.; Awazu, K. Raman and FT-IR Studies of Photodynamic Processes of Cholesteryl Oleate Using IRFELs. Nucl. Instrum. Methods Phys. Res. B 1998, 144, 229–235. [Google Scholar] [CrossRef]
- Khonakdar, H.A.; Wagenknecht, U.; Jafari, S.H.; Hässler, R.; Eslami, H. Dynamic Mechanical Properties and Morphology of Polyethylene/Ethylene Vinyl Acetate Copolymer Blends. Adv. Polym. Technol. 2004, 23, 307–315. [Google Scholar] [CrossRef]
- Jaźwiński, J. Studies on Adducts of Rhodium(II) Tetraacetate and Rhodium(II) Tetratrifluoroacetate with Some Amines in CDCl3 Solution Using 1H, 13C and 15N NMR. J. Mol. Struct. 2005, 750, 7–17. [Google Scholar] [CrossRef]
- Chen, J.; Gu, B.; LeBoeuf, E.J.; Pan, H.; Dai, S. Spectroscopic Characterization of the Structural and Functional Properties of Natural Organic Matter Fractions. Chemosphere 2002, 48, 59–68. [Google Scholar] [CrossRef]
- Budde, C.F.; Riedel, S.L.; Willis, L.B.; Rha, C.K.; Sinskey, A.J. Production of Poly(3-Hydroxybutyrate-Co-3-Hydroxyhexanoate) from Plant Oil by Engineered Ralstonia Eutropha Strains. Appl. Environ. Microbiol. 2011, 77, 2847–2854. [Google Scholar] [CrossRef]
- Morse, M.C.; Liao, Q.; Criddle, C.S.; Frank, C.W. Anaerobic Biodegradation of the Microbial Copolymer Poly(3-Hydroxybutyrate-co-3-Hydroxyhexanoate): Effects of Comonomer Content, Processing History, and Semi-Crystalline Morphology. Polymer 2011, 52, 547–556. [Google Scholar] [CrossRef]
- Chieng, B.W.; Ibrahim, N.A.; Yunus, W.M.Z.W.; Hussein, M.Z. Plasticized Poly(Lactic Acid) with Low Molecular Weight Poly(Ethylene Glycol): Mechanical, Thermal, and Morphology Properties. J. Appl. Polym. Sci. 2013, 130, 4576–4580. [Google Scholar] [CrossRef]
- Abe, H.; Doi, Y.; Kumagai, Y. Synthesis and Characterization of Poly[(R,S)-3-Hydroxybutyrate-b-6-Hydroxyhexanoate] as a Compatibilizer for a Biodegradable Blend of Poly[(R)-3-Hydroxybutyrate] and Poly(6-Hydroxyhexanoate). Macromolecules 1994, 27, 6012–6017. [Google Scholar] [CrossRef]
- Savenkova, L.; Gercberga, Z.; Nikolaeva, V.; Dzene, A.; Bibers, I.; Kalnin, M. Mechanical Properties and Biodegradation Characteristics of PHB-Based Films. Process Biochem. 2000, 35, 573–579. [Google Scholar] [CrossRef]
- Listak, J.; Jakubowski, W.; Mueller, L.; Plichta, A.; Matyjaszewski, K.; Bockstaller, M.R. Effect of Symmetry of Molecular Weight Distribution in Block Copolymers on Formation of “Metastable” Morphologies. Macromolecules 2008, 41, 5919–5927. [Google Scholar] [CrossRef]
- Gałko, G.; Sajdak, M. Trends for the Thermal Degradation of Polymeric Materials: Analysis of Available Techniques, Issues, and Opportunities. Appl. Sci. 2022, 12, 9138. [Google Scholar] [CrossRef]
- Rajaratanam, D.D.; Ariffin, H.; Hassan, M.A.; Kawasaki, Y.; Nishida, H. Effects of (R)-3-Hydroxyhexanoate Units on Thermal Hydrolysis of Poly((R)-3-Hydroxybutyrate-Co-(R)-3-Hydroxyhexanoate)s. Polym. Degrad. Stab. 2017, 137, 58–66. [Google Scholar] [CrossRef]
- Saba, N.; Jawaid, M.; Alothman, O.Y.; Paridah, M.T. A Review on Dynamic Mechanical Properties of Natural Fibre Reinforced Polymer Composites. Constr. Build. Mater. 2016, 106, 149–159. [Google Scholar] [CrossRef]
- Kosbar, L.L.; Wenzel, T.J. Inclusion of Synthetic Polymers within the Curriculum of the ACS Certified Undergraduate Degree. J. Chem. Educ. 2017, 94, 1599–1602. [Google Scholar] [CrossRef]
- Baiardo, M.; Frisoni, G.; Scandola, M.; Rimelen, M.; Lips, D.; Ruffieux, K.; Wintermantel, E. Thermal and Mechanical Properties of Plasticized Poly(L-Lactic Acid). J. Appl. Polym. Sci. 2003, 90, 1731–1738. [Google Scholar] [CrossRef]
- Murugan, P.; Gan, C.Y.; Sudesh, K. Biosynthesis of P(3HB-co-3HHx) with Improved Molecular Weights from a Mixture of Palm Olein and Fructose by Cupriavidus Necator Re2058/PCB113. Int. J. Biol. Macromol. 2017, 102, 1112–1119. [Google Scholar] [CrossRef]
- Abdelwahab, M.A.; Flynn, A.; Chiou, B.S.; Imam, S.; Orts, W.; Chiellini, E. Thermal, Mechanical and Morphological Characterization of Plasticized PLA-PHB Blends. Polym. Degrad. Stab. 2012, 97, 1822–1828. [Google Scholar] [CrossRef]
- Thiele, I.; Santolin, L.; Meyer, K.; Machatschek, R.; Bölz, U.; Tarazona, N.A.; Riedel, S.L. Microbially Synthesized Poly(Hydroxybutyrate-co-Hydroxyhexanoate) with Low to Moderate Hydroxyhexanoate Content: Properties and Applications. Int. J. Biol. Macromol. 2024, 263, 130188. [Google Scholar] [CrossRef]
- Shah, A.A.; Hasan, F.; Hameed, A.; Ahmed, S. Biological Degradation of Plastics: A Comprehensive Review. Biotechnol. Adv. 2008, 26, 246–265. [Google Scholar] [CrossRef] [PubMed]
- Choi, J.; Kim, H.; Ahn, Y.; Kim, M.; Yu, S.; Kim, N.; Lim, Y.; Park, J.; Ha, S.; Lim, S.; et al. RSC Advances Engineering for the Biodegradation of Micro-And. RSC Adv. 2024, 14, 9943–9966. [Google Scholar] [CrossRef] [PubMed]
- Hoekstra, M.; Smith, M.L. Spectrophotometric-Based Assay to Quantify Relative Enzyme-Mediated Degradation of Commercially Available Bioplastics. Polymers 2023, 15, 2439. [Google Scholar] [CrossRef] [PubMed]
- Muneer, F.; Rasul, I.; Azeem, F.; Siddique, M.H.; Zubair, M.; Nadeem, H. Microbial Polyhydroxyalkanoates (PHAs): Efficient Replacement of Synthetic Polymers. J. Polym. Environ. 2020, 28, 2301–2323. [Google Scholar] [CrossRef]

| Strains | 3HHx (mol%) | PHA Titer (g/L) | Ref. |
|---|---|---|---|
| Escherichiacoli | 13.2 | 12.9 | [25] |
| Aeromonas caviae | 25 | 27 | [26] |
| Aeromonas eutrophus (PHB⁻4/pJRDEE32d13) harboring pha | 4 | 76 | [27] |
| Cupriavidus necator Re2058/pCB113 | 19 | 73 | [28] |
| Pseudomonas putida harboring pha | 16 | 43 | [29] |
| Halomonas bluephagenesis TDC-CJ harboring pha and pha | 14.21 | 55 | [30] |
| Strain or Plasmid | Description | Ref. |
|---|---|---|
| Bacterial strains | ||
| C. necator H16 | Wild-type strain, Gm resistant | [46] |
| Re2668 | Mutant from DSM 530. Chemolithotrophic gromolh with hydrogen. Constitutive G-6-PDH. Purchasing from Korean Collection for Type Cultures (KCTC) | KCTC 2668 |
| Microbulbifer sp. SOL66 | High polyhydroxyalkanoates (PHA)-degrading strain | [45] |
| Plasmids | ||
| pCB81 | pBBR1MCS-2-based plasmid with phaCRa from Rhodococcus aetherivorans, phaJpa from Pseudomonas aeruginosa, and phaARe from Cupriavidus necator | [47] |
| Blending Ratio of the Blended Film | ||
|---|---|---|
| Samples | P(3HB) (g) | P(3HB-co-3HHx) (g) |
| P(3HB-co-3.69 mol%3HHx) | 0.5 | 0.186 |
| P(3HB-co-5.96 mol%3HHx) | 0.5 | 0.352 |
| P(3HB-co-10.56 mol%3HHx) | 1 | 0.527 |
| P(3HB-co-15.11 mol%3HHx) | 1 | 1.587 |
| Samples | Đ | |||
|---|---|---|---|---|
| Original P(3HB-co-3HHx) from microorganisms alone | P(3HB) | 84.3 | 62.6 | 1.35 |
| P(3HB-co-4.8 mol%3HHx) | 49.46 | 18.43 | 2.68 | |
| P(3HB-co-9.8 mol%3HHx) | 32.6 | 6.50 | 4.97 | |
| P(3HB-co-20 mol%3HHx) | 3.40 | 1.60 | 2.10 | |
| Blended P(3HB-co-3HHx) | P(3HB-co-3.69 mol%3HHx) | 28.63 | 4.72 | 6.06 |
| P(3HB-co-5.96 mol%3HHx) | 25.12 | 7.87 | 4.21 | |
| P(3HB-co-10.56 mol%3HHx) | 24.82 | 4.97 | 5.84 | |
| P(3HB-co-15.11 mol%3HHx) | 24.03 | 7.08 | 4.67 |
| Samples | (°C) | (°C) | ΔH (mJ/mg) | (°C) |
|---|---|---|---|---|
| Original P(3HB) | 7.5 | 171.0 | 83.9 | 68.8 |
| Blended P(3HB-co-3.69 mol%3HHx) | −2.0 | 169.3 | 75.3 | 43.0 |
| Blended P(3HB-co-5.96 mol%3HHx) | −7.5 | 161.4 | 68.6 | 43.8 |
| Blended P(3HB-co-10.56 mol%3HHx) | −8.1 | 169.4 | 40.8 | 52.9 |
| Blended P(3HB-co-15.11 mol%3HHx) | −9.1 | 172.1 | 37.5 | 51.5 |
| Original P(3HB-co-20 mol%3HHx) | −9.3 | 171.0 | 27.3 | 62.9 |
| Samples | Tensile Strength [MPa] | Young’s Modulus [MPa] | EL [%] |
|---|---|---|---|
| Original P(3HB) | 24.83 | 545.39 | 9.93 |
| Blended P(3HB-co-3.69 mol%3HHx) | 5.85 | 60.60 | 129.34 |
| Blended P(3HB-co-5.96 mol%3HHx) | 5.39 | 55.57 | 122.41 |
| Blended P(3HB-co-10.56 mol%3HHx) | 4.49 | 23.18 | 267.89 |
| Blended P(3HB-co-15.11 mol%3HHx) | 3.62 | 18.03 | 298.87 |
| Original P(3HB-co-20 mol%3HHx) | 1.82 | 10.77 | 197.14 |
Disclaimer/Publisher’s Note: The statements, opinions and data contained in all publications are solely those of the individual author(s) and contributor(s) and not of MDPI and/or the editor(s). MDPI and/or the editor(s) disclaim responsibility for any injury to people or property resulting from any ideas, methods, instructions or products referred to in the content. |
© 2024 by the authors. Licensee MDPI, Basel, Switzerland. This article is an open access article distributed under the terms and conditions of the Creative Commons Attribution (CC BY) license (https://creativecommons.org/licenses/by/4.0/).
Share and Cite
Shin, N.; Kim, S.H.; Oh, J.; Kim, S.; Lee, Y.; Shin, Y.; Choi, S.; Bhatia, S.K.; Jeon, J.-M.; Yoon, J.-J.; et al. Evaluation of Blended Poly(3-hydroxybutyrate-co-3-hydroxyhexanoate) Properties Containing Various 3HHx Monomers. Polymers 2024, 16, 3077. https://doi.org/10.3390/polym16213077
Shin N, Kim SH, Oh J, Kim S, Lee Y, Shin Y, Choi S, Bhatia SK, Jeon J-M, Yoon J-J, et al. Evaluation of Blended Poly(3-hydroxybutyrate-co-3-hydroxyhexanoate) Properties Containing Various 3HHx Monomers. Polymers. 2024; 16(21):3077. https://doi.org/10.3390/polym16213077
Chicago/Turabian StyleShin, Nara, Su Hyun Kim, Jinok Oh, Suwon Kim, Yeda Lee, Yuni Shin, Suhye Choi, Shashi Kant Bhatia, Jong-Min Jeon, Jeong-Jun Yoon, and et al. 2024. "Evaluation of Blended Poly(3-hydroxybutyrate-co-3-hydroxyhexanoate) Properties Containing Various 3HHx Monomers" Polymers 16, no. 21: 3077. https://doi.org/10.3390/polym16213077
APA StyleShin, N., Kim, S. H., Oh, J., Kim, S., Lee, Y., Shin, Y., Choi, S., Bhatia, S. K., Jeon, J.-M., Yoon, J.-J., Joo, J. C., & Yang, Y.-H. (2024). Evaluation of Blended Poly(3-hydroxybutyrate-co-3-hydroxyhexanoate) Properties Containing Various 3HHx Monomers. Polymers, 16(21), 3077. https://doi.org/10.3390/polym16213077








